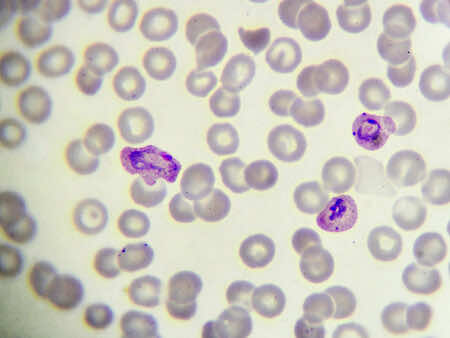
Malaria parasites, microscope, blood

MALARIA: WHAT YOU NEED TO KNOW
While we all love a tropical holiday, travel abroad always carries with it exposure to new diseases. One important disease to remember is malaria, a serious and potentially fatal disease transmitted by mosquitoes. In 2014, over 1500 people in the UK were diagnosed with the disease after travelling abroad, and at London Doctors Clinic we provide a quick and efficient service for malaria screening.
What Are The Symptoms Of Malaria?
The symptoms of malaria are very similar to the flu and can develop anytime from a week to a year after the time of infection.
Common malaria symptoms include:
- High temperature (fever)
- Chills
- Sweating
- Headaches
- Vomiting
- Muscle pains
- Diarrhoea
- Generally feeling unwell
Even if you are taking antimalarial medication, if you have the symptoms of malaria after visiting an area where malaria is common (an endemic area), you should book an appointment at a doctors surgery immediately.
What Causes Malaria?
Malaria is caused by a small parasite called Plasmodium and transmitted by mosquitoes - namely the female Anopheles mosquitoes. Female Anopheles mosquitoes bite people to obtain blood for their eggs. When they bite an infected person, they pick up the Plasmodium parasite. When the mosquito then feeds on another human, this human can become infected. The Plasmodium causes damage by causing the red blood cells in your blood to burst and even reduce the blood supply to parts of your body..
In serious cases, the lungs, liver and brain may be affected and even cause death. There are different types of Plasmodium, some causes more serious disease than others. The most dangerous type is Plasmodium Falciparum, which is most commonly found in Sub-Saharan Africa.
Malaria parasites in a blood smear, under a microscope
The ABCD of Malaria Prevention
A - Awareness of Risk of Malaria
Malaria is endemic in tropical parts of the world, including many countries in Africa, South and Central America, Asia and the Middle East.
There are many useful online resources, where you can see the malaria risk in specific countries.
Certain people are also at a higher risk of severe malaria. This includes pregnant women, children, the elderly and people with weakened immune systems. Nonetheless anyone who is planning to visit an area where there is a risk of catching malaria should speak with a GP before travel. You can book an appointment today at any of our eight central London Clinics.

World map of countries affected by malaria
B - Bite Prevention
Protecting yourself from mosquito bites is important. This includes covering your skin with long sleeves and long trousers, sleeping with mosquito nets or in an air-conditioned room and using insect repellents such as Diethyltoluamide (DEET).

Prevention is the best medicine: malaria nets reduce the risk of mosquito bites!
C - Malaria Prevention Tablets (Chemoprophylaxis)
Medication is not 100% effective against malaria but can be used alongside bite protection techniques.
If your doctor recommends that you take malaria prevention tablets, ensure that you take the right ones, at the right time and for the right length of time! Most UK travellers who get malaria, do so because they have not taken their malaria prevention tablets appropriately.
The type of medication you are advised to take will depend on where you are travelling to, the length of your stay and your own medical background. Common medications include chloroquine, doxycycline, proguanil, atovaquone and mefloquine. The most common side effects are feeling sick or having some diarrhoea. If you are using doxycycline you should also use extra sun protection as this medication can make your skin more sensitive to the sun.
As the Plasmodium parasites can develop resistance to these medications, it is important that you seek advice before each new trip abroad as the medication you used before may no longer be appropriate. You can find out more about travel clinics on our page.

Malaria prevention medications, such as doxycycline, can be taken throughout your holiday to prevent contracting of malaria
D - Diagnose and treat promptly
Malaria can be diagnosed following a blood test. The results of the test should arrive quickly so if you are found to have malaria you can start treatment straight away.
If promptly treated, most people make a full recovery from malaria. The exact medication you receive depends on a number of factors including which type of Plasmodium you are infected with and how serious your illness is. As Plasmodium can be resistant to certain medicines, several medications may be used at once or alternatives tried if the first medication that you are prescribed fails. It is common for people to feel tired and weak for a few weeks after being treated.

Malaria diagnosis is simple: lab technicians are specially trained to detect malaria parasites in blood samples
Remember, even if you are taking antimalarial medication, if you have the symptoms of malaria after visiting an area where malaria is common, you should seek medical help promptly.
You can book a same day doctor appointment with one of our private doctors. We have 12 clinics across London and countless doctors ready to help, so you should never have to travel far when you search for "doctors near me"!
By Samara Linton

